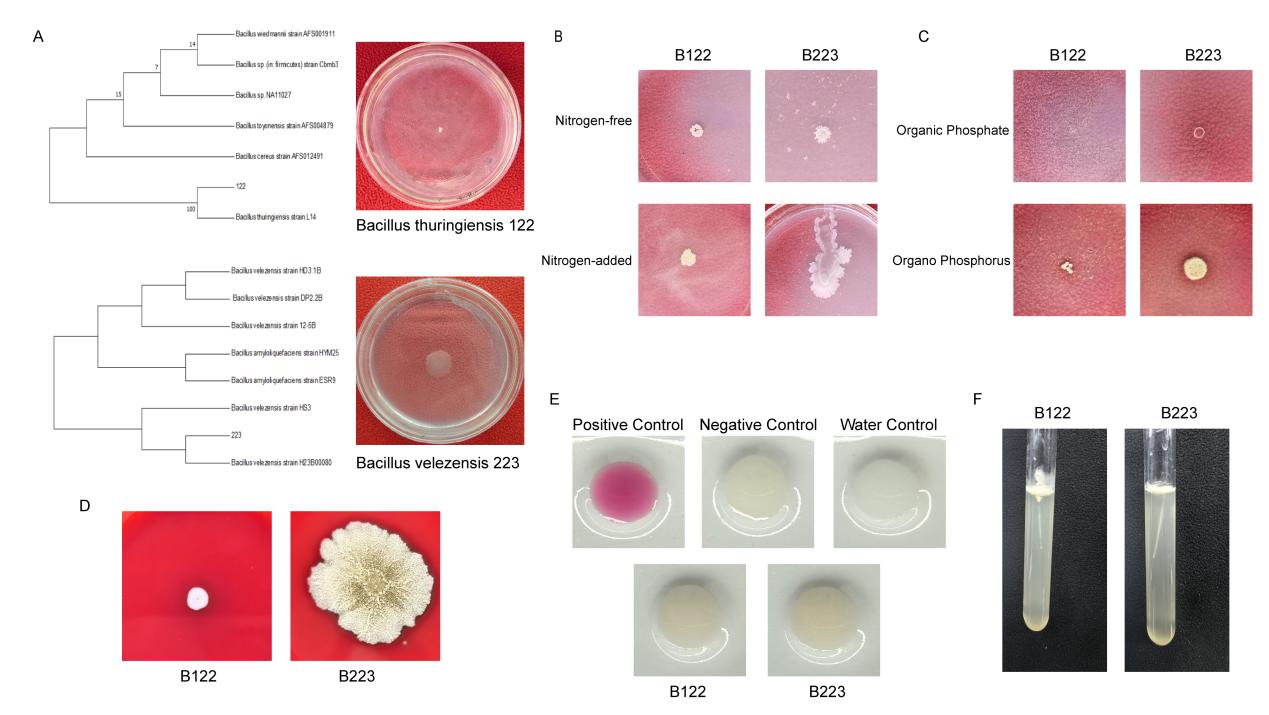
图片3.jpg

“重庆国储林专用微生物肥料创制与应用” 项目成功入选重庆市优秀职工创新项目 |
|
发布时间:2026-01-12
来源:
|
|
近日,重庆市总工会《2025年度重庆市优秀职工创新项目资助名单》公布,重庆林投公司“重庆国储林专用微生物肥料创制与应用”项目成功入选,获专项资助支持。这一荣誉既彰显了项目在国储林生态提质领域的创新价值,更是重庆市总工会对重庆林投公司职工聚焦产业痛点、深耕技术创新的有力肯定。
“重庆国储林专用微生物肥料创制与应用”项目由重庆林投公司青年科研人员安一博博士领衔的公司科研团队承担创新攻关。作为扎根国储林建设一线的科研工作者,安一博成功入选第十届中国科协青年人才托举工程。此次职工技术创新项目,他与科研团队紧盯国储林生态培育核心需求,精准聚焦国储林土壤改良与珍贵树种繁育痛点开展创新攻关。 相较于传统化肥,该项目研发的微生物肥料具有绿色环保、靶向性强等优势。通过筛选优化功能微生物菌株,构建高效稳定的菌群结构,既能减少化肥农药对林区生态的影响,又能针对性改善国储林土壤理化性质,为珍贵树种生长提供天然养分供给,助力国储林生态系统提质增效。目前,项目已依托重庆市科技局博士 “直通车” 项目重庆市松材线虫病病害防御功能微生物资源收集及调控机制研究(CSTB2024NSCQ-BSX0003)。项目前期以已成功保藏的两株高效抗病细菌菌株(保藏号:GDMCC No∶66033、66034)为核心基础,深度挖掘微生物在土壤肥力提升、病害防控中的双重作用,致力于创制适配重庆国储林生态环境的专用微生物肥料。此次市总工会资助将为菌株优化、配方调试及田间试验提供关键支撑。
图为B122和B223的鉴定及其生物控制能力测定 “国储林建设需要绿色科技赋能,工会的资助让我们的创新探索更有底气。” 安一博表示,他将与团队一道以此次资助为契机,加快专用微生物肥料的创制进程,推动技术成果在重庆国储林苗圃规模化应用,让生物防控与土壤改良技术深度融入林业生态建设,为珍贵树种高效繁育体系构建提供坚实保障。 此次专项资助不仅是对单个职工技术创新项目的精准扶持,更体现了工会组织对国储林科技创新、林业行业青年职工成长的高度关注。未来,“重庆国储林专用微生物肥料创制与应用”项目科研团队将持续深耕微生物肥料研发与应用,让科研成果真正扎根林海、服务生态,以技术创新助力重庆林业高质量发展,书写新时代基层职工的创新担当。 相关信息
|